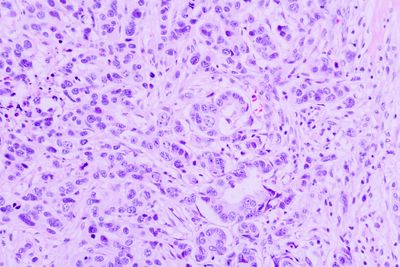
Human lung cells under the microscope

You might think that the line between life and death is clear-cut, but a growing body of research hinting at a “third state” that toes the line between the two suggests this may not be the case.
The rest of this article is behind a paywall. Please sign in or subscribe to access the full content.The so-called third state – where the cells of a dead organism continue to function after the organism's death – is the subject of a recent review from Affiliate Professor of Microbiology at the University of Washington Peter A. Noble, Dr Alex Pozhitkov at City of Hope, and coauthors.
“Life and death are traditionally viewed as opposites,” Noble told IFLScience. “However, the emergence of new multicellular lifeforms from the cells of a dead organism introduces a ‘third state’ that lies beyond the conventional boundaries of life and death.”
Essentially, their research asks the question: do our cells die when we do? The answer, it would seem, is not necessarily, as is evidenced by practices like organ, tissue, and cell transplantation. Under the right conditions – when provided with nutrients, oxygen, bioelectricity, or biochemical cues – certain cells can grow into multicellular organisms with new functions after death.
A 2021 study, for example, demonstrated that skin cells taken from dead frog embryos spontaneously reorganize into multicellular organisms called xenobots. They are able to use hair-like structures called cilia to navigate their surroundings, instead of to move mucus as is usually the case in living frog embryos.
Xenobots have also been found to replicate their structure and function without growing, in a process known as kinematic self-replication.
Similar results have been found in human lung cells, which can assemble into miniature multicellular organisms called anthrobots, move around, and even repair themselves and nearby neurons.
Cells in the third state may potentially be engineered to solve medical problems, such as serving as drug delivery systems.
Peter A. Noble
As for how this “life” after death is possible, we’re not entirely sure.
“One hypothesis is that specialized channels and pumps embedded in the outer membranes of cells serve as intricate electrical circuits,” Noble and Pozhitkov write in a piece for The Conversation. “These channels and pumps generate electrical signals that allow cells to communicate with each other and execute specific functions such as growth and movement, shaping the structure of the organism they form.”
As well as challenging our understanding of life, death, and the nature of organisms, the broader implications of the “third state” for the field of medicine could be huge, Noble explained to IFLScience: “Cells in the third state may potentially be engineered to solve medical problems, such as serving as drug delivery systems. This represents a novel and exciting avenue for medical research.”
When we began our project in 2009, we were laughed at by our colleagues. I wasn’t worried though, because if you want to discover something significant, you must venture out of the mainstream sometimes.
Alex Pozhitkov
“Exploring survival mechanisms influenced by metabolism and environmental factors could revolutionize regenerative medicine, redefine the concept of legal death, and provide new insights into the physiological limits of life – similar to the inquiries made in embryogenesis.”
Noble and Pozhitkov have been at the forefront of this research for 15 years. “When we began our project in 2009, we were laughed at by our colleagues,” Pozhitkov told IFLScience. “I wasn’t worried though, because if you want to discover something significant, you must venture out of the mainstream sometimes.”
In a paper published in 2017, the pair studied the transcriptional dynamics of dead zebrafish and mice under tightly controlled conditions. They discovered that some mRNA transcripts significantly increased in abundance several days after organismal death. “Our findings [...] were later confirmed by other research institutions. Additionally, other researchers have observed that some cells in the human brain grow after death,” said Noble.
“The question now is: why? There are many unknowns, but ongoing research is uncovering fascinating new results.”
“By addressing these questions on the mysteries of life and death, we are poised to uncover groundbreaking insights into the very fabric of life,” the team write in their review.
The review is published in Physiology.